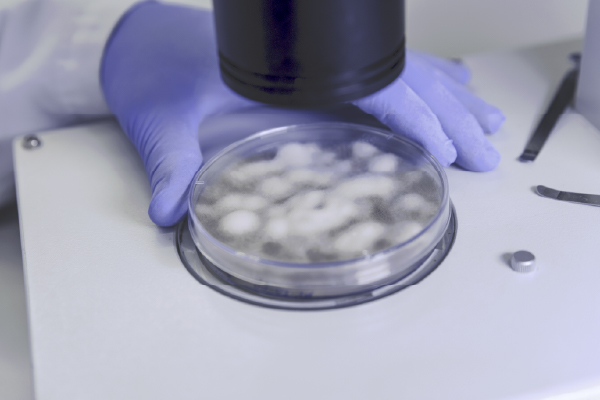
Frozen section

خدماتنا
01
التشريح المرضي النسيجي
استقبال عينات الأنسجة، التثبيت والتمرير بالشمع، إعداد المقاطع وتلوين H&E لإصدار تقرير تشخيصي دقيق.
02
الصبغات الخاصة
صبغات مثل PAS وZiehl-Neelsen وGMS لتحديد الفطريات والجراثيم والعناصر النسيجية الدقيقة.
03
الصبغات المناعية IHC
لوحات مؤشرات مناعية تشمل ER وPR وHER2 وKi-67 لتحديد النوع والمصدر بدقة.
04
الفحوص الخلوية Cytology
سوائل الجسم والمسحات وFNAC، إعداد الشرائح والتلوين وإصدار التقارير.
05
التجميد أثناء الجراحة
Frozen Section لتوجيه الجراح بنتيجة سريعة في غرفة العمليات.
06
الباثولوجيا الجزيئية
PCR وISH/FISH لتحديد الطفرات والعلامات الجزيئية الداعمة للعلاج.
07
مراجعة الشرائح
تدقيق الشرائح والتقارير الصادرة من مراكز أخرى وإصدار رأي استشاري.
08
شرائح إضافية وتصوير
تقطيع شرائح إضافية، إعادة تلوين، وتصوير مجهرى احترافي.
09
إرشادات الاستلام
مستلزمات التحويل، تعليمات التثبيت والتغليف، وتعقب العينات.
أمثلة من خدماتنا

شرائح H&E
تحضير وتلوين شرائح الهيماتوكسيلين والإيوزين بجودة عالية.

IHC
لوحات مؤشرات مناعية شاملة لتأكيد التشخيص.

سيتولوجيا
FNAC ومسحات السوائل بخطوات تحضير دقيقة.
Frozen
قطاعات مجمدة سريعة داخل غرفة العمليات.